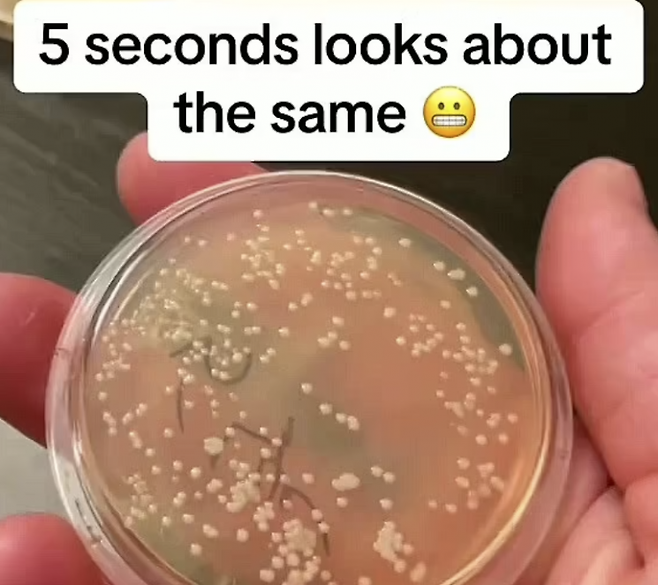
미국 미생물학자 니콜라스 아이허가 바닥에 떨어진 음식물을 1초 안에 줍더라도 박테리아가 증식할 수 있다고 주장했다. 니콜라스 아이허 사회관계망서비스(SNS) 캡처

"5초 법칙 믿었는데"…바닥에 떨어진 음식, 1초 만에 세균 '득실'
전체 맥락을 이해하기 위해서는 본문 보기를 권장합니다.
바닥에 떨어진 음식을 5초 안에 주워 먹으면 위생상 큰 문제가 없다는 '5초 법칙'과 달리 음식물이 1초만 바닥에 닿더라도 박테리아가 증식할 수 있다는 실험 결과가 나왔다.
실험 결과, 바닥에 떨어진 음식물은 '5초 법칙'과는 달리 바닥에 단 1초만 닿았던 샘플에도 흰색 박테리아가 증식한 것으로 나타났다.
이 글자크기로 변경됩니다.
(예시) 가장 빠른 뉴스가 있고 다양한 정보, 쌍방향 소통이 숨쉬는 다음뉴스를 만나보세요. 다음뉴스는 국내외 주요이슈와 실시간 속보, 문화생활 및 다양한 분야의 뉴스를 입체적으로 전달하고 있습니다.
바닥에 떨어진 음식을 5초 안에 주워 먹으면 위생상 큰 문제가 없다는 '5초 법칙'과 달리 음식물이 1초만 바닥에 닿더라도 박테리아가 증식할 수 있다는 실험 결과가 나왔다.
최근 영국 데일리메일에 따르면 미국 미생물학자 니콜라스 아이허는 바닥에 떨어뜨린 음식을 1초, 5초, 10초, 20초, 30초, 1분 단위로 주웠을 때 음식에 얼마나 많은 박테리아가 증식했는지를 실험한 결과를 공개했다.
실험은 시간대별로 채취한 샘플을 배양기에 넣어 박테리아가 얼마나 자랐는지 확인하는 방식으로 진행됐다.
실험 결과, 바닥에 떨어진 음식물은 '5초 법칙'과는 달리 바닥에 단 1초만 닿았던 샘플에도 흰색 박테리아가 증식한 것으로 나타났다.
5초 동안 바닥과 닿았던 샘플의 경우 1초 미만 동안 남겨진 샘플과 비슷한 양의 박테리아가 증식했다. 10초 동안 바닥에 놓은 샘플에서는 박테리아가 조금 더 증식했다. 20초와 30초 동안 놓은 샘플에서는 박테리아가 눈에 띄게 더 많이 증식했다. 아이허는 "'5초든 60초든, 어느 쪽도 끔찍할 것"이라고 말했다.
바닥에 닿아 박테리아 증식한 음식물을 재차 떨어뜨릴 경우 오염이 주변에 확산하는 모습도 포착됐다. 그는 실험 도중 실수로 5초 샘플을 떨어뜨렸는데, 대부분의 박테리아가 나무 테이블로 옮겨붙었다.
'5초 법칙'은 과학자마다 다양한 의견이 엇갈리는 주제다. 5초 법칙을 신뢰하는 이들은 박테리아의 이동 속도는 평균 시속 0.00045마일로, 달팽이의 이동속도의 67분의 1 수준에 불과해 떨어진 음식을 재빨리 집을수록 박테리아에 덜 오염된 음식을 먹을 수 있다고 주장한다.
다만 바닥이 습도와 재질에 따라 박테리아 증식 속도가 달라지는 만큼 떨어진 음식을 먹지 좋다는 의견이 많다. 특히 살모넬라균, 리스테리아균과 같은 박테리아는 음식에 닿자마자 즉시 증식하며 장염이나 식중독의 원인이 되는 만큼 주의하는 것이 좋다. 살모넬라균에 의해 발병하는 장티푸스는 적절한 치료를 받지 않으면 심각한 합병증으로 이어질 수 있고 리스테리아균 역시 면역력이 약한 사람들에게 패혈증, 수막염 등 유발할 수 있다.
한편 이번 실험 과정은 아이허의 사회관계망서비스(SNS)를 통해 공개됐으며 100만회 이상 조회됐다.
윤슬기 기자 seul97@asiae.co.kr
Copyright © 아시아경제. 무단전재 및 재배포 금지.
- "누드비치 아니라니까요"…알몸 관광객에 몸살 앓는 '이곳'
- "어? 김소영, 걔 아니야?"…신상공개 되자 증언 쏟아졌다
- 이재룡 '술타기 의혹', 음주측정 방해 혐의로 추가 입건
- '화장실 몰카' 찍다 잡힌 충북 장학관, 몸에 소형 카메라 3대 더 있었다
- "독도? 일본 땅이지…전 세계에 확실히 알릴 것" 다카이치의 작심발언
- "오빠 먼저 잠들어 서운"…모텔 살인 후 '자작 카톡' 보낸 김소영
- '왕사남' 신드롬에 장항준도 돈방석?…어마어마한 인센티브에 '관심'
- "커피 마시고 산책 좋았는데"…40대 '파이어족' 사무직으로 돌아갔다
- "갤럭시 쓰는 남자 싫어"…프리지아 발언에 '핸드폰 계급' 재점화
- "2000원 내고 화장실 들어가라고? 너무 과해" 카페 메뉴판 두고 '시끌'